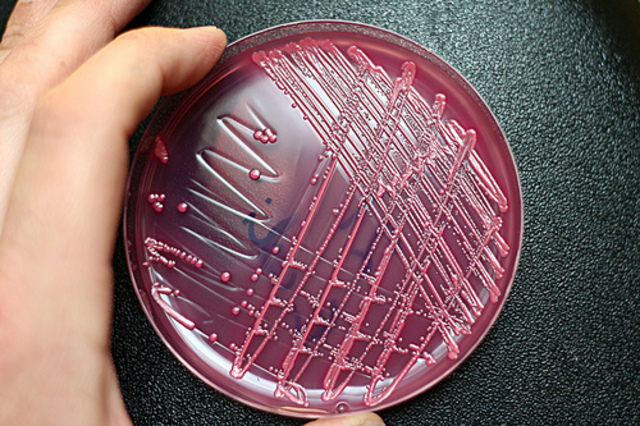
Robert Koch Begins discovery of the Connection between Bacteria and Disease

-
Isaac Singer modified Elias Howe's sewing machine when it was brought in for repairs at the machine shop where he worked. His boss suggested recreating a better version of the sewing machine instead of fixing it. After doing so, he applied for a patent in 1851 and was granted it. Singer's invention was very important to the Civil War because it helped to create more uniforms for the men to wear in battle.
http://www.northstar.k12.ak.us/schools/ryn/projects/inventors/singer/singer.html -
http://www.ask.com/pictures?l=dir&o=0&q=whitehead torpedo&qsrc=168&qid=0B4F17A43CD0C3D027E17B150B6FE9D5&pstart=27&page=4
James whitehead invented the torpedo in 1866. He was asked by scientists to create a weapon for naval warfare. He came up with a torpedo that could travel at a revised speed of 7 knots. Which was about 10 to 15 miles per hour. His invention was an immediate hit. In the civil war both the south and north used torpedoes. -
Dynamite was invented by Alfred Nobel by combining nitroglycerin and kieselgurh. Nobel first invented nitroglycerin in 1884 but it was too unstable to use. Nobel was thought that nitroglycerin would be important for explosives and expiremented with different materials to try to make the nitroglycerin. After careful testing and recording, Nobel finally discovered that nitroglycerin and kieselgurh created a stable explosive.
http://innovationzen.com/blog/2006/12/13/the-invention-of-the-dynamite/ -
The torpedo was invented by Robert Whitehead in the year 1886. He actually worked together with his 12 year old son and a workman named Annibale Ploech. The torpedo was named Minenschiff and presented to the Austrian Imperial Naval commission on December 21, 1886. Later, Robert was able to increase the torpedo's speed to 7 knots and could hit a target 700 yards away. http://en.wikipedia.org/wiki/Robert_Whitehead
-
In 1864, Gionvanni Luppis gave Robert Whitehead his plans for a self-propelled torpedo and ordered him to perfect his torpedo under a contract. Whitehead failed to do so under the contract, but afterwards he still considered it. He thought about using compressed air to fuel the torpedo, and he created the first self-propelled torpedo in 1866. He presented his torpedo, the Minenschiff, to the Austrian Naval Commission on December 21, 1866.
http://en.wikipedia.org/wiki/Torpedo -
Alfred Nobel, a famous sweedish scientist, invented the blasting cap in 1863. This invention was similar to dynamite, but was not as controllable. Nobel knew that nitroglycerin, a chemical he used in the blasting cap, was a key component in building explosives and decided to try and make it easier to use. In 1866, Nobel discovered that by mixing nitroglycerin and kieselguhr would create an explosive that was safe to use effectively. http://nobelprize.org/alfred_nobel/biographical/articles/life-
-
Christopher Latham Sholes, born on February 14, 1819 in Mooresburg, Pennsylvania, was an American inventor who invented the first practical typewriter in 1868. It was marketed by Remington Arms Company. The typewriter was a machine that was commonly used for business when there were no computers. He also created the QWERTY keyboard that had letters ordered like we have today for easier and more convenient typing. He died on February 17, 1890.
http://en.wikipedia.org/wiki/Christopher_Sholes -
In 1869 in New York, Antonio Lopez de Santa Anna introduced Tomas Adams to chicle. This was going to be a new kind of chewing gum. In 1871, Tomas Adams patented a machine for the manufacture of gum. Adams made a liquid-flavored gum called Black Jack, which was the first gum with flavor. Eventually, Adam also made a chewing gum called Tutti-Frutti which was the first gum to be sold in a vending machine. http://www.ideafinder.com/historyinventions/chewgum.htm
-
Blue Jeans are a staple in American society today. Two German immigrants invented this American classic in 1873 by combining denim, thread, and some metal into a brand new work pant. Denim had been around for centuries but Jacob Davis was the first one to create the rivets that wove the denim together into jeans. The denim was made from a cotton twill textile colored with indigo dye to make the jeans blue. Levi Strauss was a buisness man who helped pattent Jacob Davis's idea.
-
When Levi Strauss came to America, he noticed that miners and other workers were complaining about easy ripping pockets on jeans. He decided to create pants where the pockets were almost impossible to rip. On May 20, 1873, Levi Strauss recieved permission from the government to start using copper rivets so strengthen the quality of denim. And then, he and his partner began creating Levi's Jeans.
(http://www.enchantedlearning.com/inventors/1800b.shtml)
(http://en.wikipedia.org/wiki/L) -
Levi Strauss invented jeans. He patent his jeans in 1873 with hs partner Jacob Davis. The first jeans were made of cotton instead of demin. They were originally called waist overalls. Jeans were very popular in blue but also in "duck" brown.
-
Isolates the bacteria causing vibriocholera and the bacteria causing tuberculosis. This meant that Koch basically found the link between bacteria and disease. He was Awarded the Nobel Prize in Medicine in 1905. Is considered on of the founders of Microbiology. This is relevant to the Civil War because many of the deaths in the war were caused by bacterial infection in wounds they got from battle.
-
Eadweard Muybridge became famous for his landscape pictures and one day took a wager that a horse would have all four legs up at the same time. In 1878, he set up an experiment with 12 of his stereoscopic cameras with 21 inches apart for 20 feet to photograph a horse through a run. After developing his pictures, he saw that the horse had all 4 legs off at the same time and put them in motion.
(http://en.wikipedia.org/wiki/Eadweard_Muybridge) -
Although Edward Leveaux did not truly invent the Automatic Player Piano, he patened it so that it could work by itself without any manual help. He was the one who received the patent first, and although there were others proclaiming to be the inventor, he received the patent first on Oct. 4, 1881. Information:
http://www.brainyhistory.com/events/1881/october_4_1881_60476.html
Image:
http://en.wikipedia.org/wiki/Player_piano&usg=__J7zY8mpi3PVV1hOlWcHa6BtXmtc=&h=264&w=180&sz=9&hl=en&start=29&tbn -
In 1887, Heinrich Hertz placed an oscillator (thing that moves up and down) in front of a zinc plate. Why? Because, using small rings that could detect waves, he proved that waves can actually travel through the air. This experiment made four foot long waves through the air. In addition, he recorded the polarity and intensity of the fields. These observations eventually led to the invention of radio and radar by others.
http://en.wikipedia.org/wiki/Heinrich_Hertz#Electromagnetic_research
Want to make a timeline like this?
Use Timetoast to turn dates, events, milestones, and phases into a clear visual timeline you can build and share. Timetoast is a timeline maker for work, school, research, and stories.